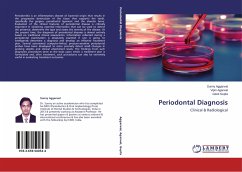

Suchergebnisse für ""Aggarwal""
1533 Artikel gefunden
Zur ersten SeiteZur vorherigen Seite...Weitere Seiten 5 Zur Seite 5 6 Zur Seite 6 7 Zur Seite 7 8 Aktuelle Seite 9 Zur Seite 9 10 Zur Seite 10...Weitere Seiten31Zur letzten Seite, Seite 31Zur nächsten SeiteZur letzten Seite
Zur ersten SeiteZur vorherigen Seite...Weitere Seiten 7 Zur Seite 7 8 Aktuelle Seite...Weitere Seiten31Zur letzten Seite, Seite 31Zur nächsten SeiteZur letzten Seite
Ähnlichkeitssuche: Fact®Finder von OMIKRON